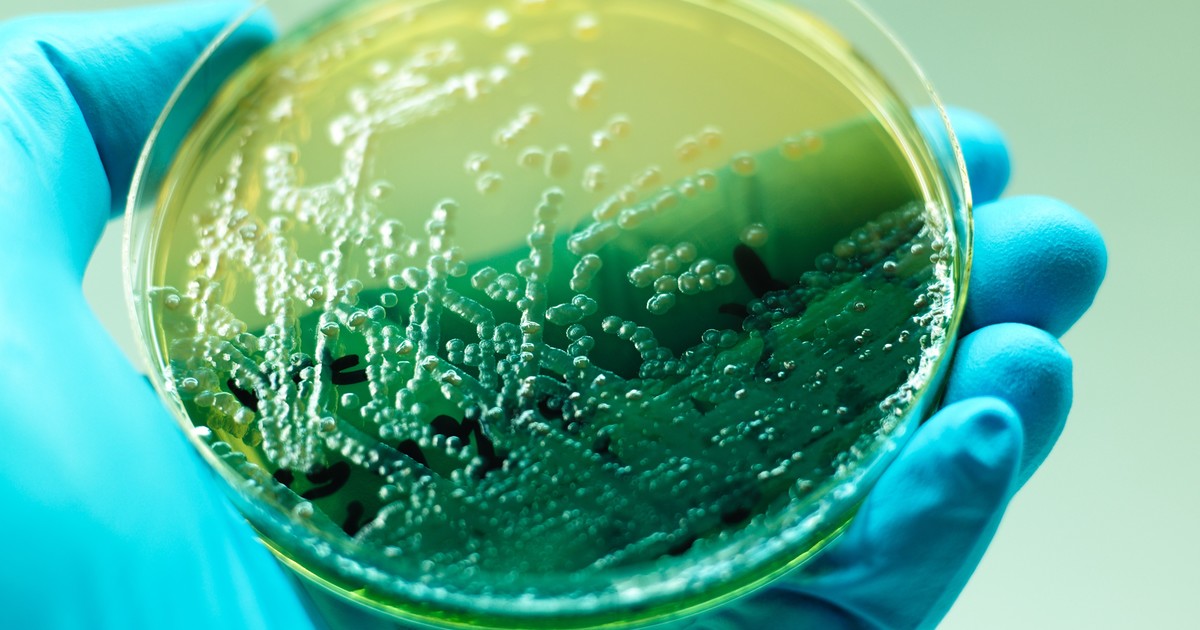

-
Generales

Alerta máxima estas 12 ciudades de Estados Unidos por una nueva tormenta devastadora
El fenómeno climático afectará a la costa atlántica central y el noreste.Prevén más de 30 centímetros de nieve, ventisca e inundaciones....
-
Generales

Choques en la Ciudad: en Boedo un auto de aplicación embistió a un taxi, lo hizo volcar y hay cuatro heridos
En menos de una hora se originaron tres accidentes con vuelcos. Los otros dos fueron en la Autopista 25 de Mayo y en el barrio de Las Cañitas.Hubo otros cuatro heridos, entre ellos un nene de 8 años...
-
Generales

Los primeros trabajos que van a desaparecer por la IA, según Elon Musk
Para Musk, en unos años trabajar podría convertirse en una opción y no en una necesidad: ¿a qué se refiere?Todas las predicciones del magnate....
-
Generales

Villa Gesell: un joven de 28 años murió al caer con su moto desde un médano
Andrés Alberto Alemán era de Ensenada. Según se informó, circulaba sin casco.Días atrás una influencer de La Plata había sufrido un grave accidente con un UTV....
-
Generales

Es oficial: en Arizona, la gobernadora Katie Hobbs anunció la expansión de la banda ancha
Arizona consiguió la aprobación final para activar millones de dólares en obras de conectividad.¿Qué busca el plan?...
-
Generales
Hallan un misterioso ARN que no pertenece a virus ni bacterias, pero está dentro de nosotros
Se encuentra presente en el microbioma humano y distinto a cualquier forma de vida conocida.Qué función cumple y por qué este descubrimiento podría cambiar lo que se sabe sobre la biología....
-
Generales

Los 5 mejores ejercicios para incrementar la masa muscular
Con el paso del tiempo, la masa muscular tiende a disminuir si no recibe estímulos adecuados.Así, el entrenamiento orientado a su incremento cumple un rol clave en el mantenimiento de la funcionalid...
-
Generales

Milei retoma visitas a las provincias y ya piensa en un compañero de fórmula para reemplazar a Villarruel
En el gabinete hay ministros que reclaman anuncios de medidas para reactivar la economía. Regreso a EE.UU. y el discurso del 1 de marzo, en agenda. ...
-
Generales

Presos políticos en Venezuela: el chavismo evalúa otorgar "medidas de gracia" e indultos para los excluidos en la Ley de Amnistía
Lo informó el presidente del Parlamento, Jorge Rodríguez, ante los reclamos de familiares de personas que no cumplen con los requisitos de la norma.Sostuvo que hasta el momento se recibieron más de...
-
Generales

Eclipse lunar del 3 de marzo 2026: a qué hora es y en qué lugares se verá la "Luna de Sangre"
Es el primer eclipse lunar de 2026, y el segundo eclipse de este año. En su fase total, será uno de los fenómenos más largos del año.Qué es una "Luna de Sangre", cuánto durará y cómo verla....
-
Generales

El otro lado de Andy Warhol
Nada especial, de Nicole Flattery, es una novela de iniciación y un retrato del costado menos conocido del artista estadounidense....
-
Generales

Javier Milei y sus medidas, EN VIVO: todas las novedades del Gobierno, minuto a minuto
El oficialismo apunta a convertir en ley la reforma laboral y el nuevo código penal juvenil....
-
Generales

Lionel Messi, furioso contra el árbitro tras el debut del Inter Miami en la MLS: lo fue a buscar a su vestuario y lo tuvo que frenar Luis Suárez
El argentino se quejó por la falta de sanción para sus rivales, que se movieron sistemáticamente para cometerle infracciones.Mirá el video....
-
Generales

Descubren al menos 20 obras desconocidas que Miguel Ángel salvó de su destrucción
Se descubrió que Miguel Ángel no quemó su legado como siempre se ha creído.Ideó un plan para salvar bocetos y esculturas entregándolos a amigos y discípulos....


